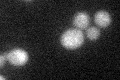
YPL021W

View description
Non-essential protein of unconfirmed function; affects pre-rRNA processing, may act as a negative regulator of the transcription of genes involved in pseudohyphal growth; homologous to Srd1p
Localization:
Intensity:
Fold change:
Significance:
-
C’ GFP library in SD

below threshold16.68 -
N' NOP1pr-GFP in SD

N/A0 -
N' TEF2pr-mCherry in SD

N/A0 -
N' NATIVEpr-GFP in SD

N/A0 -
N' TEF2pr-VC and Cyto-VN in SD

N/A0 -
C’ GFP library in SD+DTT
cytosol14.520.87No -
C’ GFP library in SD+H2O2

cytosol14.610.87No -
C’ GFP library in Starvation Media

cytosol14.550.87No -
C’ GFP library on the background of Pup2-DaMP

below threshold -
C’ GFP library on the background of CCT mutant

below threshold16.71531.00149No
